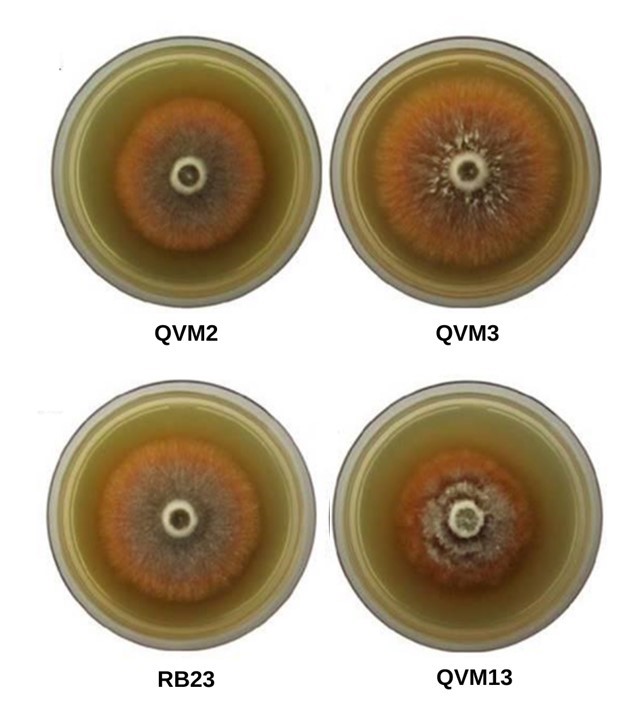

- Proposed
- Under Assessment
- Preliminary Assessed
- DDAssessed
- 5Published
Leucocoprinus attinorum S. Urrea-Valencia, A. Rodrigues & R.J. Bizarria
- Scientific name
- Leucocoprinus attinorum
- Author
- S. Urrea-Valencia, A. Rodrigues & R.J. Bizarria
- Common names
- IUCN Specialist Group
 Mushroom, Bracket and Puffball
Mushroom, Bracket and Puffball- Kingdom
- Fungi
- Phylum
- Basidiomycota
- Class
- Agaricomycetes
- Order
- Agaricales
- Family
- Agaricaceae
- Assessment status
- Assessed
- Preliminary Category
- DD
- Proposed by
- Salomé Urrea Valencia
- Assessors
- Salomé Urrea Valencia, Maria Eduarda de Andrade Borges, Andre Rodrigues, Pepijn Kooij, Rodolfo Bizarria Jr., luis fries, Luciana da Canêz, Patricia Fiuza
- Reviewers
- E. Ricardo Drechsler-Santos, Kelmer Martins da Cunha, Diogo H. Costa-Rezende
Assessment Notes
Justification
Leucocoprinus attinorum é o fungo mutualista de pelo menos cinco espécies de formigas que praticam o tipo de fungicultura basal, dentro da subtribo Attina (Hymenoptera, Formicidae, Attini) (Schultz, 2020). Estas formigas compreendem, Mycocepurus goeldii Forel, 1893, Mycetophylax asper Mayr, 1887, Mycetagroicus cerradensis Brandão & Mayhé-Nunes, 2001, Mycetagroicus inflatus Brandão & Mayhé-Nunes, 2008 e Cyatta abscondita Sosa-Calvo et al., 2013. As populações das espécies de formigas que de fato cultivam Lc. attinorum, ocorrem em fragmentos de borda de plantações de eucalipto, em Anhembi - SP; fragmentos remanescentes de Mata Atlântica, em Chapecó - SC; áreas de vegetação típica de Cerrado em Uberlândia - MG e Brasília - DF e áreas inundáveis do rio Araguaia com predominância de Floresta Aluvial Densa, no Pará. Visto que uma espécie de formiga atínea pode cultivar mais de uma linhagem fúngica (Mehdiabadi et al., 2012), a distribuição de Lc. attinorum não pode ser estimada a partir da distribuição geográfica das formigas parceiras, o que dificulta calcular o tamanho populacional deste fungo. Além disso, a formação de basidiomas de Lc. attinorum fora do cuidado das formigas é potencialmente raro e, em associação com as formigas, estas controlam a reprodução sexuada do fungo mutualista (Mueller 2002; Shik et al. 2016; Bizarria et al. 2021). Neste sentido, o número de indivíduos maduros conhecidos de Lc. attinorum, é calculado a partir do tamanho das populações de formigas que o cultivam, estimando-se um número de 6100 indivíduos maduros em 2025 (considerando a data de coleta dos espécimes de Lc. attinorum). Contudo, o tamanho populacional total (conhecido e estimado) não pode ser calculado com precisão, e o mesmo deve ser maior do que o conhecido, visto que as populações se encontram geograficamente separadas por uma distância de até 2.700 km, mas não foram monitoradas nos últimos anos, impedindo verificar se houve algum declínio ou aumento do número de indivíduos maduros. As ameaças para Lc. attinorum ainda são desconhecidas, e portanto sua tendência populacional não pode ser inferida, resultando na impossibilidade de propor uma categoria de ameaça para a espécie. Leucocoprinus attinorum é classificada como Dados Deficientes.
Taxonomic notes
Leucocoprinus attinorum S. Urrea-Valencia, A. Rodrigues & R.J. Bizarria Mycological Progress 22 (9, no. 66): 11 (2023) (MycoBank # 838174; Tipo: FLOR68411). Seu epíteto faz referência à subtribo Attina (Hymenoptera, Formicidae, Attini).
Why suggested for a Global Red List Assessment?
Leucocoprinus attinorum é uma das duas espécies até agora descritas para formigas atíneas basais (subtribo Attina), as quais cultivam como fonte de alimento, fungos pertencentes ao gênero Leucocoprinus (Agaricales, Agaricaceae). Este número é díspar frente às 85 espécies de formigas que praticam o tipo de fungicultura basal da subtribo Attina. Isso se deve ao fato de que, em associação com as formigas, o fungo raramente produz basidiomas, estrutura indispensável na caracterização taxonômica de Agaricales. Assim, a identidade taxonômica dos fungos cultivados pelas atíneas permanece pouco explorada, o que dificulta a avaliação do estado de conservação das espécies.
Nesse contexto, a presente proposta representa a primeira aproximação para avaliar o estado de conservação de linhagens fúngicas cultivadas por formigas atíneas, bem como evidencia que não há dados suficientes a respeito da distribuição geográfica e do tamanho populacional de Lc. attinorum, o que representa uma das principais razões para avaliar este táxon.
Geographic range
Leucocoprinus attinorum foi descrita a partir de isolados do jardim de fungos coletados em diferentes colônias de Mycocepurus goeldii, no borde de uma plantação de eucalipto, em Anhembi, São Paulo. Assim, sua distribuição conhecida limita-se a essa área. Contudo, com base em sequências de ITS depositadas na base de dados do NCBI-GenBank, Lc. attinorum ocorre associada a mais quatro espécies de atíneas (dados não publicados; Sosa-Calvo et al., 2017): Mycetophylax asper (Chapecó, Santa Catarina), Mycetagroicus cerradensis (Uberlândia, Minas Gerais), Mycetagroicus inflatus (região oriental do estado do Pará) e Cyatta abscondita (Brasília, Distrito Federal) (Sosa-Calvo et al., 2013; Sosa-Calvo et al., 2017; Solomon et al., 2011; Jesovnik et al., 2013). Esses dados suportam a distribuição potencial de Lc. attinorum (Sosa-Calvo et al., 2017), totalizando cinco locais de ocorrência, os quais se encontram separados entre si por uma distância de até 2700 km. Ainda é importante destacar que embora M. goeldii apresente ampla distribuição no Brasil, e em outros países como Argentina (Kempf, 1963), Paraguai, Bolívia (Janicki et al., 2016) e Guayana (Mackay et al., 2004), não é possível estimar a distribuição de Lc. attinorum com base na distribuição de M. goeldii, visto que esta formiga pode cultivar mais de uma espécie fúngica.
Population and Trends
A espécie é conhecida em uma localidade, representada por 24 isolados do jardim de fungo de M. goeldii, com um total de cinco coleções obtidas pela formação in vitro de basidiomas. Adicionalmente, há potencialmente mais quatro populações com base em sequências de ITS de cultivares de quatro espécies de formigas, totalizando cinco estados brasileiros onde Lc. attinorum ocorre, sendo eles Minas Gerais, Santa Catarina, Distrito Federal, Pará e São Paulo (Sosa-Calvo et al., 2017; Solomon et al., 2011; Sosa-Calvo et al., 2013; Jesovnik et al., 2013). A identificação de indivíduos maduros de Lc. attinorum em seu habitat é impossibilitada, pois a espécie ocorre como cultivar de diferentes espécies de formiga e, até o momento, seus basidiomas só foram observados a partir de indução in vitro. Considerando os táxons hospedeiros de Lc. attinorum, o número de rainhas potenciais em uma colônia representa o número de indivíduos maduros (UICN 2001; 2012; 2024). Portanto, este valor pode ser extrapolado para o tamanho populacional de Lc. attinorum, considerando que cada rainha funda uma colônia carregando o parceiro fúngico, e que ambos os organismos são estritamente dependentes (Fernández-Marín et al., 2004). Dessa forma, a partir das ocorrências conhecidas de Lc. attinorum, infere-se que para 2025, o número de indivíduos maduros é de 6100 (considerando a probabilidade de 2% de sucesso de formação de uma nova colônia, 10 potenciais rainhas para as colônias das formigas hospedeiras e o número de anos desde o registro de cada ocorrência de Lc. attinorum). Contudo, o tamanho populacional estimado não pode ser calculado com precisão, e o mesmo deve ser maior do que o conhecido, já que a probabilidade de sucesso de novas colônias foi estimada para formigas atíneas derivadas (Autuori, 1950). Além disso, são escassos os registros da distribuição de Lc. attinorum e das espécies de formigas associadas que de fato cultivam esta espécie, além da distância geográfica entre as populações de formigas onde foi coletado Lc. attinorum.
Population Trend: Uncertain
Habitat and Ecology
Com base nos registros de Leucocoprinus attinorum cultivado por cinco populações de formigas atíneas basais (M. goeldii, M. asper, M. cerradensis, M. inflatus e C. abscondita), a espécie ocorre em fragmentos antropizados de plantações de eucalipto; fragmentos remanescentes de Mata Atlântica (contendo Floresta Ombrófila Mista e Floresta Estacional Decidual); áreas de vegetação típica de Cerrado e áreas inundáveis do rio Araguaia com predominância de vegetação do tipo Floresta Aluvial Densa. Pela disponibilidade de dados moleculares, Lc. attinorum é uma espécie endêmica do Brasil.
Threats
As populações de fungos leucocoprinoides (Agaricaceae, Leucocoprineae) são altamente sensíveis à fragmentação de hábitat (Vellinga, 2004). Apesar disso, Lc. attinorum cultivado pela população de M. goeldii pode ocorrer na borda de plantações de eucalipto, porém as relações entre a ocupação desses ambientes e as dinâmicas populacionais de Lc. attinorum não são bem entendidas. Para o caso das populações de Lc. attinorum cultivadas por M. asper, M. cerradensis e C. abscondita infere-se que a fragmentação de hábitat não seja um problema direto para a espécie, visto que as coleções das colônias foram realizadas respectivamente, dentro da Floresta Nacional de Chapecó - FLONA Chapecó (Sosa-Calvo et al., 2017), na Reserva Ecológica do Panga em Uberlândia (Solomon et al., 2011) e Fazenda Água Limpa da Universidade de Brasília (Sosa-Calvo et a., 2013), sendo estas representadas por fragmentos de mata circundados por áreas antropizadas. Por último, a população de Lc. attinorum cultivada por M. inflatus pode sofrer maior perda de qualidade de hábitat, pois os poucos registros existentes foram realizados em áreas de várzea do rio Araguaia, o qual pertence à bacia do rio Amazonas. O rio Araguaia é um dos rios tropicais de grande porte mais ameaçados (Mangueira; Santos, 2024), devido à rápida transformação do ecossistema causado pelo desmatamento, para uso como terras agrícolas e de pastagem (Coe et al., 2011; Latrubesse et al., 2009).
Conservation Actions
O principal desafio para acessar o estado de conservação e consequentemente promover ações, é esclarecer a distribuição geográfica de Lc. attinorum, sendo necessário incrementar o número de pesquisas e esforço amostral, para então definir o número real de populações de Lc. attinorum no Brasil. Enquanto isso, proteger as áreas conhecidas da distribuição das espécies de atíneas que cultivam Lc. attinorum, contribuirá diretamente com a sua potencial conservação.
Research needed
Obter basidiomas de Lc. attinorum em condições in vitro é dispendioso, mas continua sendo recomendado para estudar a variabilidade morfológica da espécie. A forma simplificada de identificação é por análise de DNA, assim, futuras pesquisas que incluam análises moleculares do fungo mutualista encontrado em colônias de M. goeldii, M. asper, M. cerradensis, M. inflatus e C. abscondita, bem como de outras espécies de formigas atíneas basais, serão fundamentais para elucidar a distribuição de Lc. attinorum. Adicionalmente, destaca-se a necessidade de incrementar estudos taxonômicos em Leucocoprinus, monitorando diferentes áreas do Brasil, pois este esforço permitirá esclarecer se existe um potencial real de Lc. attinorum ocorrer fora do cuidado das formigas atíneas que o cultivam. Com um melhor entendimento da biologia e distribuição da espécie, as potenciais ameaças a sua população serão esclarecidas.
Use and Trade
Nenhum conhecido.
Bibliography
AUTUORI, M. Contribuição para o conhecimento da. Saúva (Am: spp. - Hymenaptera — Formicidae). V — Número de formas aladas e redução dos sauveíros iniciais. Instituto Biológico de São Paulo, v. 19, p. 325—331, 1950.
BIZARRIA, R.; KOOIJ, P. W.; RODRIGUES, A. Climate change influences basidiome emergence of leaf-cutting ant cultivars. Journal of Fungi, v. 7, n. 11, p. 912, 2021. DOI: https://doi.org/10.3390/jof7110912.
COE, M. T.; LATRUBESSE, E. M.; FERREIRA, M. E.; AMSLER, M. L. The effects of deforestation and climate variability on the streamflow of the Araguaia River, Brazil. Biogeochemistry, v. 105, n. 1–3, p. 119–131, 2011. DOI: https://doi.org/10.1007/s10533-011-9582-2
FERNANDEZ-MARIN, H.; ZIMMERMAN, J. K.; WCISLO, W. T. Ecological Traits and Evolutionary Sequence of Nest Establishment in Fungus-Growing Ants (Hymenoptera, Formicidae, Attini). Biological Journal of the Linnean Society, 81, 39–48, 2004. DOI: https://doi.org/10.1111/j.1095-8312.2004.00268.
UICN. 2024. Diretrizes para o Uso das Categorias e Critérios da Lista Vermelha da UICN. Versão 16. Preparada pelo Comitê de Padrões e Petições. Disponível em https://www.iucnredlist.org/resources/redlistguidelines
IUCN. 2012. IUCN Red List Categories and Criteria: Version 3.1. Second edition. Gland, Switzerland and Cambridge, UK: IUCN. Available at http://www.IUCNredlist.org/technical-documents/categories-and-criteria
IUCN. 2001. IUCN Red List Categories and Criteria: Version 3.1. IUCN Species Survival Commission. IUCN, Gland, Switzerland and Cambridge, U.K.
JANICKI, J.; NARULA, N.; ZIEGLER, M.; GUÉNARD, B.; ECONOMO, E. P. Visualizing and interacting with large-volume biodiversity data using client-server web-mapping applications: the design and implementation of antmaps.org. Ecological Informatics, v. 32, p. 185–193, 2016. DOI: https://doi.org/10.1016/j.ecoinf.2016.02.006
JESOVNIK, A.; SOSA-CALVO, J.; LOPES, C. T.; VASCONCELOS, H. T.; SCHULTZ, T. R. Nest architecture, fungus gardens, queen, males and larvae of the fungus-growing ant Mycetagroicus inflatus Brandão & Mayhé-Nunes. Insectes Sociaux, v. 60, p. 531–542, 2013. DOI: doi.org/10.1007/s00040-013-0320-8
KEMPF, W. W. A review of the ant genus Mycocepurus Forel, 1893 (Hymenoptera: Formicidae). Studia Entomologica, v. 6, p. 417–432, 1963.
LATRUBESSE, E. M.; AMSLER, M. L.; MORAIS, R. P.; AQUINO, S. The geomorphologic response of a large pristine alluvial river to tremendous deforestation in the South American tropics: the case of the Araguaia River. Geomorphology, v. 113, n. 3–4, p. 239–252, 2009. DOI: https://doi.org/10.1016/j.geomorph.2009.03.014.
MACKAY, W. P.; MAES, J. M.; ROJAS FERNÁNDEZ, P.; LUNA, G. The ants of North and Central America: the genus Mycocepurus (Hymenoptera: Formicidae). Journal of Insect Science, v. 4, p. 27, 2004. DOI: https://doi.org/10.1673/031.004.2701
MANGUEIRA, J.; SANTOS, I. Plano de Conservação para a bacia do rio Araguaia. The Nature Conservancy Brasil. 2024. Disponível em: https://www.tnc.org.br/content/dam/tnc/nature/en/documents/brasil/Resumo_Executivo_português.pdf. Acesso em: 24 out. 2025
MEHDIABADI, N. J.; MUELLER, U. G.; BRADY, S. G.; HIMLER, A. G.; SCHULTZ, T. R. Symbiont fidelity and the origin of species in fungus-growing ants. Nature Communications, v. 3, p. 840, 2012. DOI: https://doi.org/10.1038/ncomms1844.
MUELLER, U. G. Ant versus fungus versus mutualism: ant-cultivar conflict and the deconstruction of the attine ant-fungus symbiosis. The American Naturalist, v. 160, supl. S67–S98, 2002. DOI: https://doi.org/10.1086/342084.
SCHULTZ, T. R. Fungus-Farming Ants (Attini in Part). In: Starr, C. Encyclopedia of Social Insects. 1–8. Cham, Switzerland: Springer International Publishing. 2020.
SHIK, J. Z.; GOMEZ, E. B.; KOOIJ, P. W.; SANTOS, J. C.; WCISLO, W. T.; BOOMSMA, J. J Nutrition mediates the expression of cultivar farmer conflict in a fungus growing ant. Proceedings of the National Academy of Sciences of the United States of America, v. 113, p. 10121–10126, 2016. DOI: https://doi.org/10.1073/pnas.1606128113
SOLOMON, S.E.; LOPES, C.T.; MUELLER, U.G.; RODRIGUES, A.; SOSA-CALVO, J.; SCHULTZ, T.R.; VASCONCELOS, H.L. Nesting biology and fungiculture of the fungus-growing ant, Mycetagroicus cerradensis: New light on the origin of higher attine agriculture. Journal of Insect Science, v. 11, art. 12, p. 1-14, 2011.
SOSA-CALVO, J.; JESOVNIK, A.; VASCONCELOS, H. L.; BACCI JR., M.; SCHULTZ, T. R. Rediscovery of the enigmatic fungus-farming ant “Mycetosoritis” asper Mayr (Hymenoptera: Formicidae): implications for taxonomy, phylogeny, and the evolution of agriculture in ants. PLoS ONE, v. 12, e0176498, 2017. DOI: https://doi.org/10.1371/journal.pone.0176498
SOSA-CALVO, J.; SCHULTZ, T. R.; BRANDÃO, C. R. F.; KLINGENBERG, C.; FEITOSA, R. M.; RABELING, C. et al. Cyatta abscondita: Taxonomy, Evolution, and Natural History of a New Fungus-Farming Ant Genus from Brazil. PLoS ONE, v. 8, n. 11, e80498, 2013. DOI: https://doi.org/10.1371/journal.pone.0080498
VELLINGA, E. C. Ecology and distribution of lepiotaceous fungi (Agaricaceae) - A review. Nova Hedwigia, v. 78, p. 273-299, 2004. DOI: 10.1127/0029-5035/2004/0078-0273
URREA-VALENCIA, S.; JÚNIOR, R. B.; KOOIJ, P. W.; MONTOYA, Q. V.; RODRIGUES, A. Unraveling fungal species cultivated by lower attine ants. Mycological Progress, v. 22, n. 9, p. 66, 2023. DOI: https://doi.org/10.1007/s11557-023-01912-6
Country occurrence
Regional Population and Trends
| Country | Trend | Redlisted |
|---|